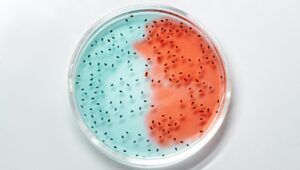
pexels-edward-jenner-4033022-e1763225719850-300x170.jpg

L’Agenzia caraibica per la sanità pubblica (CARPHA) riafferma il proprio impegno nella lotta alla resistenza antimicrobica (AMR) nella regione unendosi alla comunità globale nel riconoscere la Settimana mondiale di sensibilizzazione sulla resistenza antimicrobica (WAAW). CARPHA afferma in una pubblicazione che la resistenza antimicrobica è sempre più…
Il post CARPHA celebra la settimana globale di sensibilizzazione sulla resistenza antimicrobica (AMR): i progressi regionali nella lotta contro la resistenza antimicrobica sono apparsi per la prima volta su Dominica News Online.